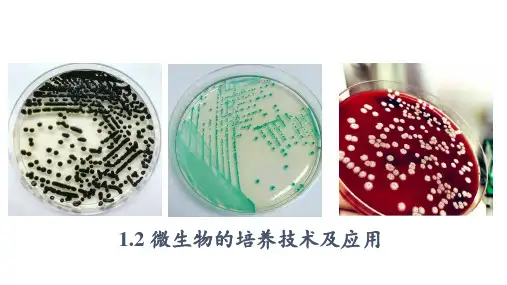

高中生物微生物的培养与应用
- 格式:ppt
- 大小:1.73 MB
- 文档页数:27

2020届高考生物难点及易错题精讲精练专题12 微生物的培养和应用【难点精讲】一、微生物的实验室培养和无菌技术例题:(2018·全国Ⅱ,37)在生产、生活和科研实践中,经常通过消毒和灭菌来避免杂菌的污染。
回答下列问题:(1)在实验室中,玻璃和金属材质的实验器具___________(填“可以”或“不可以”)放入干热灭菌箱中进行干热灭菌。
(2)牛奶的消毒常采用巴氏消毒法或高温瞬时消毒法,与煮沸消毒法相比,这两种方法的优点是_____________________________________________________________________________。
(3)密闭空间内的空气可采用紫外线照射消毒,其原因是紫外线能_______________________。
在照射前,适量喷洒________,可强化消毒效果。
(4)水厂供应的自来水通常是经过________(填“氯气”“乙醇”或“高锰酸钾”)消毒的。
(5)某同学在使用高压蒸汽灭菌锅时,若压力达到设定要求,而锅内并没有达到相应温度,最可能的原因是____________________。
【答案】(1)可以(2)在达到消毒目的的同时,营养物质损失较少(3)破坏DNA结构消毒液(4)氯气(5)未将锅内冷空气排尽【解析】(1)干热灭菌是指将物品放入干热灭菌箱内,在160~170 ℃条件下加热1~2 h。
耐高温、需要保持干燥的物品,如玻璃器皿(吸管、培养皿)和金属用具等,可采用干热灭菌的方法。
(2)巴氏消毒法是在70~75 ℃条件下煮30 min或在80 ℃条件下煮15 min,可以杀死牛奶中的微生物,并且使牛奶的营养物质损失较少。
(3)接种室、接种箱或超净工作台在使用前,可以用紫外线照射30 min,紫外线能破坏微生物的DNA结构,以杀死物体表面或空气中的微生物。
在照射前,适量喷洒石炭酸或煤酚皂溶液等消毒液,可以强化消毒效果。

微生物的培养及应用微生物的培养及应用是现代生物技术和微生物学研究领域中的重要内容。
通过培养微生物,可以利用其在生物学、医学、环境保护和工业领域等各个方面的应用。
关于微生物的培养方面,可以从以下几个方面介绍:一、微生物的培养方法微生物的培养方法主要包括液体培养和固体培养两种方式。
液体培养是将微生物培养在液体培养基中,通常是在培养皿或培养瓶中进行。
液体培养适合于需大量培养的微生物,可以通过离心等方法将微生物与培养基分离。
固体培养则是将微生物培养在固体培养基上,通常是在琼脂培养基上进行。
固体培养可以利用菌落形态和菌落特性进行鉴定和分离。
二、微生物的培养技术微生物的培养技术主要包括纯化培养、分离培养和维持培养。
纯化培养是将微生物从混合培养中分离出来,通常通过稀释液体培养基、分层分离等方法进行。
分离培养是将微生物从单一菌落中分离出来,通常是通过挑取菌落、划线法等方法进行。
维持培养则是将微生物保持在培养基中,并确保其存活和生长。
三、微生物的应用领域微生物在生物技术、医学、环境保护和工业领域等各个方面都有广泛应用。
在生物技术领域,微生物被广泛应用于基因工程、发酵工程、酶工程等方面,如利用大肠杆菌进行基因克隆和表达、利用酵母菌进行蛋白质表达等。
在医学领域,微生物被用于分离和鉴定病原微生物、制备抗生素等。
在环境保护领域,微生物被用于生物修复、生物气氛污染物降解等。
在工业领域,微生物被用于食品加工、饲料生产、废弃物处理等。
四、微生物的培养和利用中存在的问题和挑战微生物的培养和利用中存在一系列问题和挑战,主要包括以下几个方面:首先,微生物的培养条件需要精确控制,包括培养基的配方、温度、氧气、pH值等。
其次,微生物的培养过程中可能出现感染、菌株变异等问题,需要进行严密的监控和检测。
此外,微生物的应用也面临着法规、道德和安全等方面的限制和考虑。
总之,微生物的培养及应用是一个涉及广泛的领域,通过合理的培养方法和技术,可以获得高质量的微生物菌种,并利用其在各个领域中发挥作用。

高中生物选修一微生物的培养与应用高中生物选修一微生物的培养与应用微生物是一类微小的生物体,包括细菌、真菌、病毒等,广泛存在于自然界的各个环境中。
高中生物选修一中,学生将学习关于微生物的培养与应用的知识,这些知识将帮助学生理解微生物的重要性和应用领域。
在微生物培养方面,学生将学习培养微生物的基本方法,包括使用培养基、控制温度和湿度等。
他们将学习如何从自然环境中收集微生物样本,如土壤、水、食物等,以及如何对这些样本进行分离和培养。
通过实验,学生将了解微生物的生长规律以及培养条件对微生物生长的影响。
此外,学生还将学习微生物的应用。
微生物在医学、工业和环境等领域有着广泛的应用。
在医学领域,学生将了解微生物在疾病诊断和治疗中的应用,例如微生物检测、抗生素的生产等。
在工业领域,学生将学习微生物在食品生产、酿酒和发酵过程中的应用。
在环境领域,学生将了解微生物在土壤改良、废水处理和生物除臭等方面的应用。
学生还将学习如何利用微生物进行实验研究。
他们将学习如何通过实验设计和实施,研究微生物的生长规律、代谢特性和基因组结构等方面的内容。
通过这些实验,学生将培养实验设计和数据分析的能力。
微生物的培养与应用对于培养学生的科学思维和实验技能具有重要意义。
通过学习微生物的培养与应用,学生将更好地理解微生物的重要性和应用领域,为他们今后的科学学习和研究奠定基础。
此外,微生物的研究和应用也对于解决环境和医学等领域的问题具有重要意义。
总之,高中生物选修一微生物的培养与应用是一门重要的课程,它将帮助学生了解微生物的培养方法、应用领域以及实验研究方面的能力。
这门课程对于培养学生的科学素养和实验技能具有重要意义,同时也为学生今后的科学研究和应用领域的发展奠定基础。

高中微生物培养与运用教案教学内容:微生物的培养与运用教学目标:1. 了解微生物的概念,掌握微生物的培养方法;2. 掌握微生物的运用领域,了解微生物在生活、工作中的作用;3. 培养学生的实验操作能力和科学研究意识。
教学重点难点:1. 微生物的培养方法;2. 微生物在生活、工作中的应用。
教学准备:1. 实验室用具:培养皿、接种环、显微镜等;2. 实验材料:琼脂培养基、细菌接种液等。
教学过程:第一课时一、导入(5分钟)1. 讲解微生物的概念,引导学生思考微生物的种类和作用。
二、培养微生物实验(20分钟)1. 将琼脂培养基加热至液态状态,倒入培养皿中;2. 用接种环取少量细菌接种液,在琼脂培养基上划线;3. 将培养皿置于恒温培养箱中培养一段时间。
三、实验分析(10分钟)1. 观察培养皿中的微生物生长情况;2. 讨论微生物在生活、工作中的应用。
第二课时一、复习(5分钟)1. 回顾上节课的内容,强化学生对微生物培养的理解。
二、讲解微生物的运用(15分钟)1. 讲解微生物在食品工业、医药领域的应用;2. 引导学生讨论微生物在环境保护中的作用。
三、探究实验(20分钟)1. 设计实验,探究微生物在土壤改良中的作用;2. 学生自行操作实验,记录实验数据。
四、总结(10分钟)1. 学生展示实验结果,并进行讨论;2. 强调微生物在生活中的重要性,激发学生对微生物的学习兴趣。
教学反思:通过本次教学,学生对微生物的培养方法和运用有了更深入的理解,也了解了微生物在生活中的重要作用。
在今后的教学中,可以结合更多实际案例,引导学生深入探究微生物的神秘世界,激发他们的科学探究兴趣。



专题二微生物的培养与应用课题一微生物的实验室培养·培养基:人们按照微生物对营养物质的不同需求,配制出供其生长繁殖的营养基质,是进行微生物培养的物质基础。
·培养基按照物理性质可分为液体培养基半固体培养基和固体培养基。
在液体培养基中加入凝固剂琼脂(是从红藻中提取的一种多糖,在配制培养基中用作凝固剂)后,制成琼脂固体培养基。
微生物在固体培养基表面生长,可以形成肉眼可见的菌落。
根据菌落的特征可以判断是哪一种菌。
液体培养基应用于工业或生活生产,固体培养基应用于微生物的分离和鉴定,半固体培养基则常用于观察微生物的运动及菌种保藏等。
·按照成分培养基可分为人工合成培养基和天然培养基。
合成培养基是用成分已知的化学物质配制而成,其中成分的种类比例明确,常用于微生物的分离鉴定。
天然培养基是用化学成分不明的天然物质配制而成,常用于实际工业生产。
·按照培养基的用途,可将培养基分为选择培养基和鉴定培养基。
选择培养基是指在培养基中加入某种化学物质,以抑制不需要的微生物生长,促进所需要的微生物的生长。
鉴别培养基是根据微生物的特点,在培养基中加入某种指示剂或化学药品配制而成的,用以鉴别不同类别的微生物。
·培养基的化学成分包括水、无机盐、碳源、氮源、生长因子等。
·碳源:能为微生物的代谢提供碳元素的物质。
如CO2、NaHCO3等无机碳源;糖类、石油、花生粉饼等有机碳源。
异养微生物只能利用有机碳源。
单质碳不能作为碳源。
·氮源:能为微生物的代谢提供氮元素的物质。
如N2、NH3、NO3-、NH4+(无机氮源)蛋白质、氨基酸、尿素、牛肉膏、蛋白胨(有机氮源)等。
只有固氮微生物才能利用N2。
·培养基还要满足微生物生长对pH、特殊营养物质以及氧气的要求。
例如,培养乳酸杆菌时需要在培养基中添加维生素,培养霉菌时须将培养基的pH调至酸性,培养细菌是需要将pH调至中性或微碱性,培养厌氧型微生物是则需要提供无氧的条件·无菌技术·获得纯净培养物的关键是防止外来杂菌的入侵,要注意以下几个方面:①对实验操作的空间、操作者的衣着和手,进行清洁和消毒。


专题2课题1微生物的实验室培养
一、课题目标
1.知识目标
a.了解有关培养基的基础知识。
b.了解消毒和灭菌方法。
2.能力目标
a.进行无菌技术操作。
b.进行微生物培养。
3.情感目标
形成勇于实践、严谨求实的科学态度和科学精神。
二、课题重点
无菌技术操作。
三、课题难点
无菌技术操作。
四教学流程
水、碳源、氮源、无机盐
问题2:从细胞的化学元素组成来看,培养基中为什么都含有这些营养成分?
C、H、O、N、P、S是构成细胞原生质的基本元素,约占原生质总量的97%以上。
【小结】共同归纳培养基的基本成分和主要来源。
(2)特殊成分和条件
提醒学生培养基还需要满足不同微生物生长对PH、氧气、特殊营养物质的要求:如乳酸杆菌时需要添加维生素,霉菌需要将培养基pH调节为酸性,细菌时需要将pH调节为中性或微碱性。
(二)无菌技术
讲解:无菌操作泛指在培养微生物的操作中,所有防止杂菌污染的方法。
强调无菌操作是培养微生物成功的关键。
1.主要方面
讲解无菌技术主要方面:
(1)对实验操作空间、操作者的衣着和手进行清洁和消毒;
(2)将培养器皿、接种用具和培养基等器具进行灭菌;
(3)为避免周围微生物污染,实验操作应在酒精灯火焰附近旁进行;(4)避免已灭菌处理的材料用具与周围物品相接触。
2.消毒与灭菌的比较
列表让学生进行比较。

专题二微生物的培养与应用1.实验室培养微生物需要解决哪两方面的问题?液体培养基和固体培养基的作用分别是什么?培养基中应具备哪些营养物质?实验室培养微生物要解决两方面问题:(1)需要为培养的微生物提供合适的营养和环境条件;(2)防止外来杂菌的入侵。
液体培养基的作用:广泛应用于实验研究及大规模工业生产中,有利于广泛获得大量菌体或代谢产物。
固体培养基的作用:广泛应用于微生物的分离培养、菌种鉴定和保藏。
培养基一般都含有水、碳源、氮源和无机盐。
2.霉菌和细菌适宜的pH分别是什么?消毒和灭菌的区别是什么?培养霉菌时需将培养基的pH调至酸性;培养细菌时需将pH调至中性或微碱性。
消毒是指使用较为温和的物理或化学方法杀死物体表面或内部的部分微生物(不包括芽孢和孢子)。
灭菌是指使用强烈的理化因素杀死物体内外所有的微生物,包括芽孢和孢子。
3.消毒和灭菌方法分别有哪些?适用范围分别是什么?实验室中常用的消毒方法:巴氏消毒法(如牛奶)、化学药制进行消毒(如酒精擦拭双手、氧气消毒水源)、实验室还用紫外线或化学药物消毒(如接种室、接种箱或超净工作台)、煮沸消毒法。
实验室中常用的灭菌方法: 灼烧灭菌(如接种环、接种针、或其他金属用具)、干热灭菌(如玻璃器皿、吸管、培养皿和金属用具)、高压蒸汽天菌(培养基)。
4.配制牛肉膏蛋白胨固体培养基的操作步骤是?什么时候调节叫值?平板为什么要倒置?配制牛肉膏蛋白胨固体培养基的操作步骤:计算一称量+溶化→灭菌→倒平板。
调pH值应该在溶化后,灭菌前。
平板冷凝后,皿盖上会凝结水珠。
将平板倒置,可以防止皿盖上的水珠落入培养基造成污染。
5.平板划线法的操作过程是什么?平板划线法的操作流程:(1)将接种环放在火焰上灼烧,直到接种环烧红;(2)在火焰旁冷却接种环,并打开盛有菌液的试管的棉塞;(3)将试管口通过火焰;(4)将已冷却的接种环伸入菌液中,沾取一环菌液;(5)将试管口通过火焰,并塞上棉塞;(6)左手将皿盖打开一条缝隙,右手将沾有菌种的接种环迅速伸入平板内,划三至五条平行线,盖上皿盖。
考点47 微生物的培养和应用高考频度:★★★☆☆难易程度:★★★☆☆1.培养基(1)概念:人们按照微生物对营养物质的不同需求,配制出供其生长繁殖的营养基质。
(2)营养组成:一般都含有水、碳源、氮源和无机盐。
此外,还需要满足微生物生长对pH、氧气以及特殊营养物质的要求。
(3)种类:按照物理性质可分为液体培养基和固体培养基。
2.无菌技术(1)含义:指在培养微生物的操作中,所有防止杂菌污染的方法。
(2)关键:防止外来杂菌的入侵。
(3)不同对象的无菌操作方法(连线)3.大肠杆菌的纯化培养(1)制备牛肉膏蛋白胨固体培养基①操作步骤计算→称量→溶化→灭菌→倒平板②倒平板的方法及注意事项a.请用文字和箭头写出正确的倒平板操作流程:丙→乙→甲→丁。
b.甲、乙、丙中的灭菌方法是灼烧灭菌。
c.丁中的操作需要等待平板冷却凝固才能进行。
(2)纯化大肠杆菌的方法①纯化培养原理:想方设法在培养基上得到由一个细菌繁殖而来的肉眼可见的菌落,即可获得较纯的菌种。
②纯化大肠杆菌的关键步骤是接种。
③常用的微生物接种方法有两种a .平板划线法:是通过接种环在琼脂固体培养基表面连续划线的操作,将聚集的菌种逐步稀释分散到培养基的表面。
b .稀释涂布平板法:是将菌液进行一系列的梯度稀释,然后将不同稀释度的菌液分别涂布到琼脂固体培养基的表面,进行培养。
系列稀释操作(如图所示):涂布平板操作(如图所示):(3)菌种的保存方法①对于频繁使用的菌种,可以采用临时保藏的方法。
②对于需要长期保存的菌种,可以采用甘油管藏的方法。
4.土壤中分解尿素的细菌的分离与计数(1)分离原理:土壤中的细菌之所以能分解尿素,是因为它们能合成脲酶,这种物质在把尿素分解成无机物的过程中起到催化作用。
(2)统计菌落数目:统计样品中的活菌一般用稀释涂布平板法。
(3)实验流程:土壤取样→样品的稀释→微生物的培养与观察→细菌的计数。
5.分解纤维素的微生物的分离(1)纤维素酶①组成:纤维素酶是一种复合酶,一般认为它至少包括三种组分,即C 1酶、C X 酶和葡萄糖苷酶。